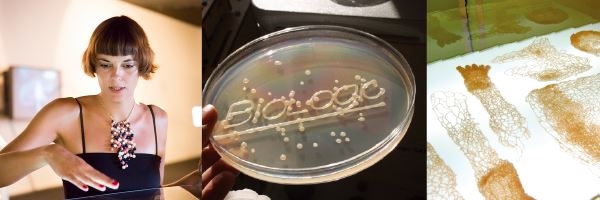

期待到荷蘭感受一下設計嗎?
這次讓荷蘭設計師陪著您一起發想囉
手把手不藏私
藉著體驗社會設計的過程
自然而然 從關懷出發的美好力量
Atelier NL / Lonny van Ryswyck
關於本地行動&關注事物靈魂與真實性的概念
-
Studio Maarten Kolk & Guus Kusters
帶著風景中的詩意 善於轉換&意義深遠的設計
-
Raw color / Daniera ter Haar & Christoph Brach
善於以實驗將自然轉換為設計語彙
-
Sonja bäumel
結合藝術與科學為一體 科幻與現實的呈現
-
以荷蘭設計師風格為導向的工作坊,
由設計師帶入各自擅長的設計方法,延續前日座談探討主題,
帶領學員,尋找與大自然相關,與未來相關發展的創作可能性,
並邀請台灣設計師一同設計體驗!
透過實際體驗社會設計的觀察與思考,一同創作,並於工作坊後進行發表交流。
(詳細內容請參考後面講師介紹)
自然而然─台灣x荷蘭社會設計展 Natural to Next Natural工作坊
地點:台北實踐大學(台北市大直街70號)
時間:6/30(一),09:30~17:30
09:00~09:30 報到
09:30~12:00 分組討論
13:00~16:30 設計實作
16:30~17:30 發表
---------------------------------------------------
[報名流程]
1.本網頁報名並填寫希望的講師順位。
2.等候通知,繳交500元保證金並回覆後,即報名成功。(加開報名者請於6/26完成匯款,當日結束後退還,匯款帳戶將寄至信箱)
3.建議6/29(日)10:00 參加台北當代藝術館講座,搶先了解講師的設計想法&看展,為工作坊暖身。
(報名已額滿)
4.滿懷期待6/30(一)到實踐大學台北校區參加工作坊吧!
---------------------------------------------------
[6/29講座訊息 台北當代藝術館] (報名已額滿)
10:15~10:30 開場 策展人徐景亭(Gina Hsu)
10:30~11:20 Atelier NL / Lonny van Ryswyck/荷蘭設計師
11:25~12:15 Studio Maarten Kolk & Guus Kusters/荷蘭設計師
13:30~14:00 水越設計 周育如 (Agua Chou)
14:10~15:00 Sonja bäumel/荷蘭設計師
15:10~16:00 Raw color Daniera ter Haar & Christoph Brach/荷蘭設計師
16:10~17:00 竅門設計 王俊隆 (Rock Wang) & 何忠堂(Tong Ho)
[展覽訊息]
自然而然 - 台灣x荷蘭社會設計展 Natural to Next Natural
2014/06/14~07/20
台北當代藝術館 MOCA Studio
每週二至週日(Tue-Sun),10:00-18:00
每週一休館 Closed on Mondays
本展免費參觀
[講師介紹]
Atelier NL / Lonny van Ryswyck
NL工作室是由蘭妮‧凡‧瑞斯瑞克(1978)與娜汀‧史德克(1977)這二位設計師所組成的,她們都於2006年畢業於安荷芬設計學院,畢業作包含了《針織燈》與《源自於陶土》等創作,而後她們一起於安荷芬市的一間小教堂內成立工作室。
NL工作室特別著重於真實性這個概念,並時常提出關於形式從何而來,以及它們受那些元素所支撐等問題。設計師將設計視為於時間中漫遊的一種旅程,並且關注所有事物的靈魂、身份以及所蘊含的生命精髓。為了掌握時代的精神,她們總是試圖往事物的最深處開鑿。「這中間所包含的遠遠超過設計本身: 我們的作品嘗試著將不同的元素結合。考量到我們周邊環境的歷史過程,我們會思考所採用的媒材純粹度,並且將本地行動的能量一同納入。我們研究所有的事物,但同時在我們所做的一切裡保有自我。在歷史與我們所處的時空中,賦予事物適當的位置。」
http://www.ateliernl.com/

Studio Maarten Kolk & Guus Kusters
馬丁‧庫克 (1980) 與葛斯‧庫斯特爾斯 (1979) 於2009年開始合作。他們投身於自發性的計畫以並擔任展覽設計師與策展人。自然界、歷史、色彩以及風景中所發現的詩意,是他們創作的靈感來源。他們試圖將這些發現轉換於物件、媒材應用、展覽以及創新製作手法中。他們的作品曾於倫敦蘇富比、恩克赫伊森南海博物館、蒂爾堡織品博物館、博伊曼斯‧布尼根博物館、霍隆設計博物館展出,也被多家美術館與私人藏家珍藏。
http://maartenkolk-guuskusters.tumblr.com/

Raw color / Daniera ter Haar & Christoph Brach
作品《原色》透過平面設計與攝影的結合反映出媒材與色彩混合的精密處理。透過一連串的研究與實驗的過程,衍生與架構其中所呈現的視覺語彙。丹妮拉‧德‧哈爾與克里斯托夫‧巴拉赫的工作室位於荷蘭安荷芬市,他們在此工作室進行自己發起或是受委任的創作案件。
http://www.rawcolor.nl/

Sonja bäumel
索妮雅‧巴烏莫目前於維也納與阿姆斯特丹居住與工作。她的作品結合藝術與科學、時尚與科學、設計與科學,界於服裝與身體、科幻與現實之間。她的作品源自於對於科學數據及事實的長期關注,而她自己也時常進行實驗,並在實驗室進行相關研究。
曾就讀於維也納時裝設計學院,巴烏莫擁有奧地利林茲藝術大學的藝術學士學位,並取得安荷芬設計學院的概念設計碩士。2012年她的作品《紡織解剖學》獲得BMUKK維也納聯邦政府教育,藝術和文化部門所頒發的傑出藝術與實驗設計獎。
http://www.sonjabaeumel.at/
[交通方式]
捷運
1.文湖線:大直站1號出口右轉大直街步行約5分鐘。
2.淡水線:圓山站1號出口至「捷運圓山站」公車站轉乘21、208、247、287、紅2往大直內湖方向路線公車至北安路「捷運大直站」。
3.板南線:忠孝復興站轉乘捷運文湖線(往南港展覽館)至大直站1號出口。
公車
1.至北安路「捷運大直站」公車路線:21、28、33、42、72、208、222、247、256、267、286(副)、287、646、902、紅2、紅3、棕13、棕16。
2.至明水路「大直加油站」公車路線:33、42、645、紅3、藍12。

指導單位 台北市文化局
主辦單位 台北當代藝術館
共同主辦 青沐設計工作室 東海醫院設計工作室
特別感謝 荷蘭貿易暨投資辦事處 文心建築 實踐大學
指定投影 EPSON 3LCD
活動問題請洽 193.dhhs@gmail.com


